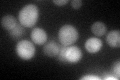
YHR055C
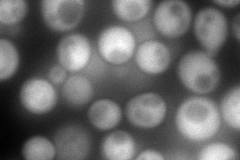
YHR055C
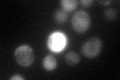
YHR055C

View description
Metallothionein, binds copper and mediates resistance to high concentrations of copper and cadmium; locus is variably amplified in different strains, with two copies, CUP1-1 and CUP1-2, in the genomic sequence reference strain S288C
Localization:
Intensity:
Fold change:
Significance:
-
C’ GFP library in SD
cytosol50.15 -
N' NOP1pr-GFP in SD
cytosol248.331 -
N' TEF2pr-mCherry in SD

missing0 -
N' NATIVEpr-GFP in SD

below threshold17.7446 -
N' TEF2pr-VC and Cyto-VN in SD

cytosol81.1371 -
C’ GFP library in SD+DTT

cytosol60.781.21No -
C’ GFP library in SD+H2O2
cytosol70.851.41Yes -
C’ GFP library in Starvation Media

cytosol57.671.14No -
C’ GFP library on the background of Pup2-DaMP

cytosol -
C’ GFP library on the background of CCT mutant

cytosol29.39630.586052Yes
